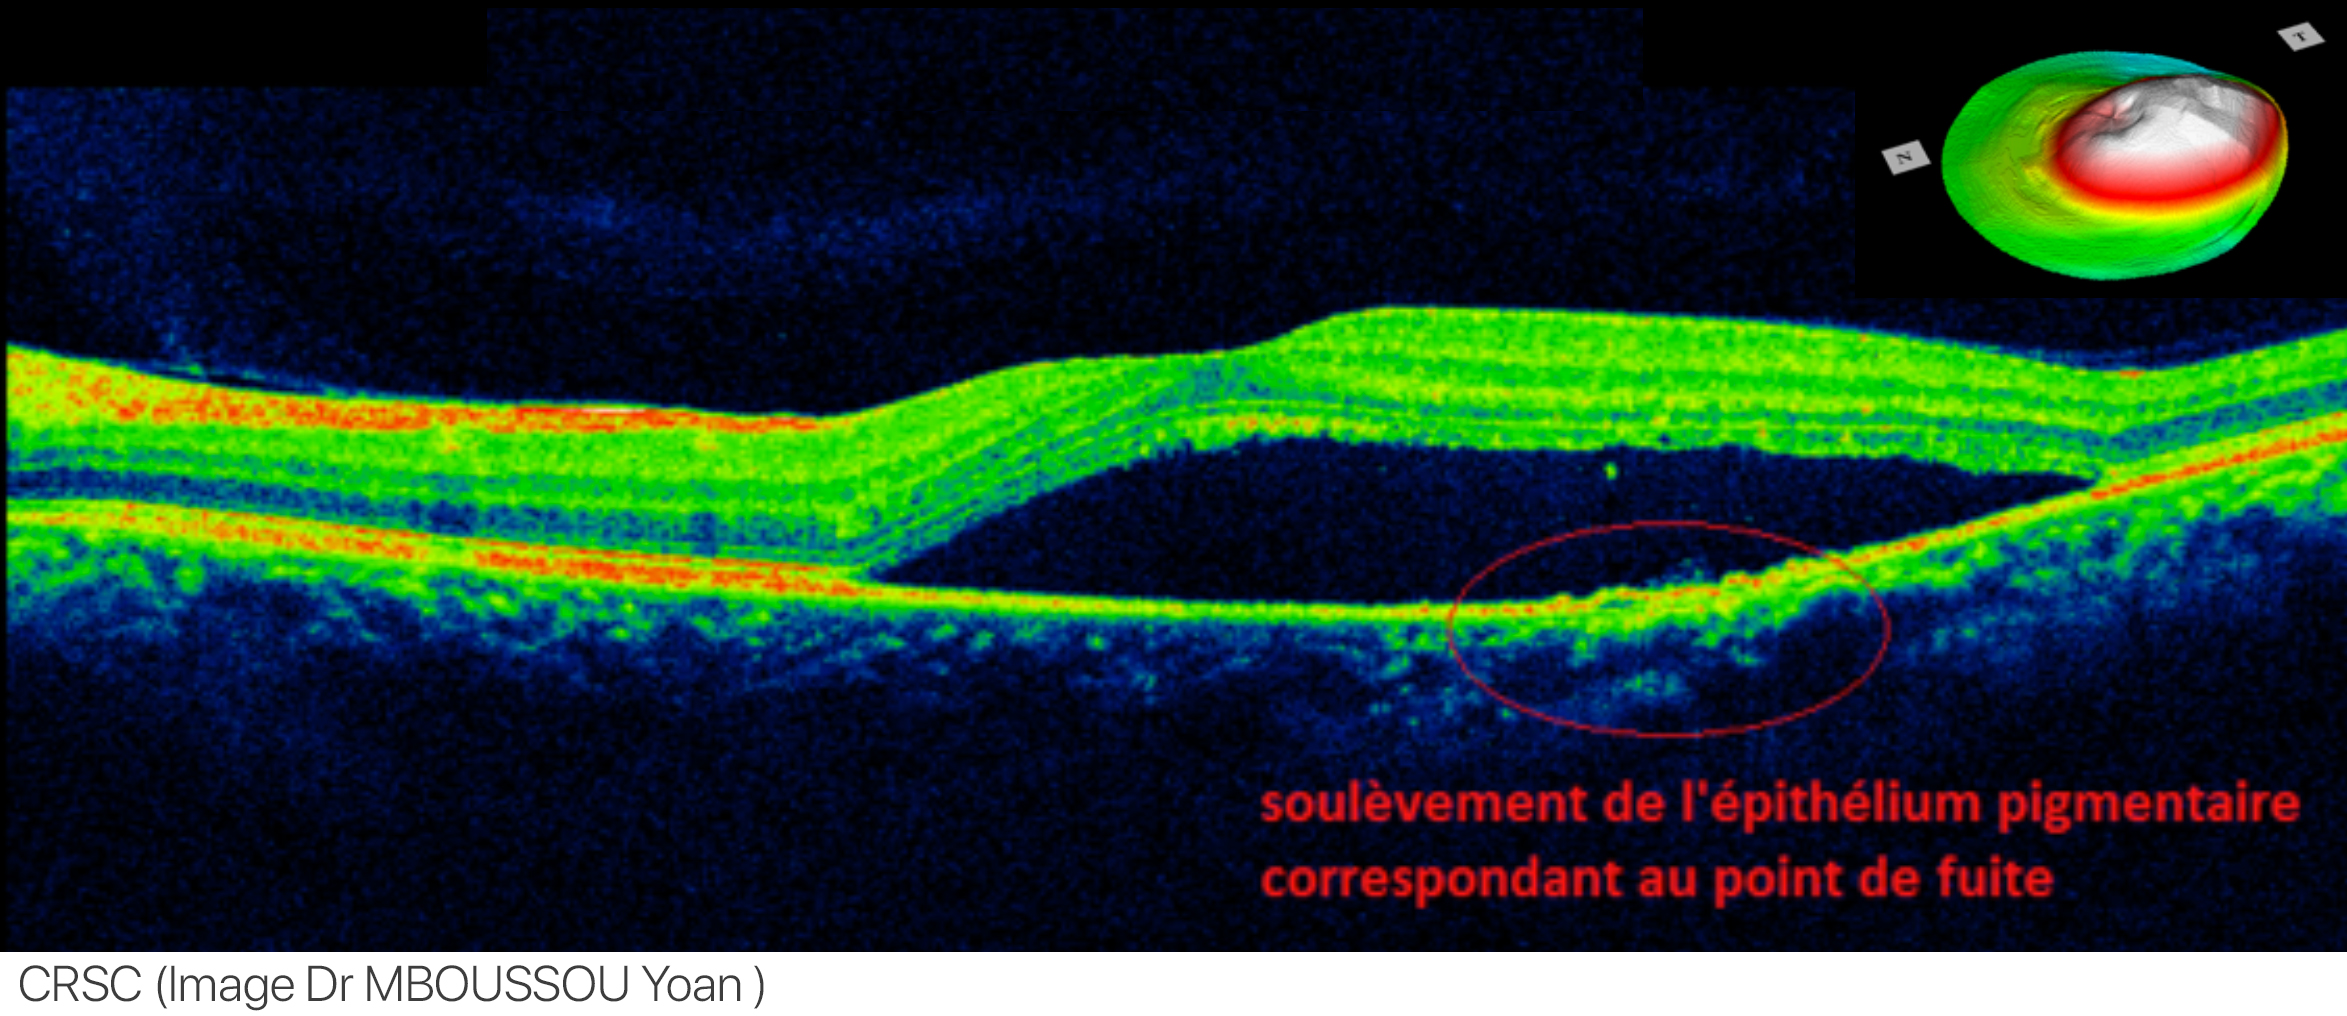

중심장액성망막증
"오늘의AI위키"의 AI를 통해 더욱 풍부하고 폭넓은 지식 경험을 누리세요.
1. 개요
중심장액성망막증은 눈의 황반 아래 체액이 고여 시력 저하를 유발하는 질환이다. 정확한 원인은 불분명하나 스트레스, 코르티코스테로이드 사용, 헬리코박터 파일로리 감염 등이 관련될 수 있다. 맥락막 비후 스펙트럼의 한 단계로 이해되기도 하며, 시야 왜곡, 시력 저하 등의 증상을 보인다. 진단은 안저 촬영, 빛간섭 단층 촬영 등을 통해 이루어지며, 대부분 자연 치유되지만 일부 환자에게는 레이저 치료, 약물 치료가 필요할 수 있다.
더 읽어볼만한 페이지
| 중심장액성망막증 | |
|---|---|
| 질병 개요 | |
| 이름 | 중심 장액 맥락망막병증 |
| 영어 이름 | Central serous chorioretinopathy |
| 증상 | 시력 저하 변시증 (사물이 찌그러져 보이는 증상) 중심 암점 (시야의 일부가 보이지 않는 증상) |
| 합병증 | 맥락막 신생혈관 망막 색소 상피 위축 |
| 발병 시기 | 다양함 |
| 지속 기간 | 다양함 |
| 원인 | 불명확, 스트레스, 스테로이드 사용 등과 관련 가능성 |
| 위험 요인 | 남성 임신 A형 행동 유형 고혈압 쿠싱 증후군 자가면역 질환 위산 과다 이식 |
| 진단 방법 | 안저 검사 광간섭 단층촬영 (OCT) 형광 안저 혈관 조영술 |
| 감별 진단 | 중심와 맥락망막병증 망막 혈관 폐쇄 망막 색소 상피 박리 맥락막 신생혈관 |
| 예방 | 스트레스 관리, 스테로이드 사용 자제 |
| 치료 | 경과 관찰 레이저 광응고술 광역학 요법 (PDT) 항혈관내피 성장인자 (anti-VEGF) 주사 |
| 약물 | 항혈관내피 성장인자 (anti-VEGF) 제제 |
| 예후 | 대부분 자연적으로 호전되나, 재발 가능성 존재 |
| 빈도 | 비교적 흔함 |
| 추가 정보 | |
 | |
2. 원인
중심장액성망막병증은 눈에 영양을 공급해주는 망막 미세 혈관(모세 혈관, Retinal pigment epithelium)이 미세하게 파열되어, 시력의 중심 부위인 황반 아래의 조직에 고여 황반이 이탈되는 질환이다. 정확한 원인은 아직 밝혀지지 않았지만, 스트레스, 수면 부족, 예민한 성격 등이 영향을 미치는 것으로 알려져 있다.[37]
스트레스는 중심장액성망막병증의 주요 발병 요인 중 하나로,[38] 스트레스가 많은 직업군에서 발병률이 높다는 보고도 있지만, 확실하지는 않다.
코르티솔 및 코르티코스테로이드와의 관련성도 보고된다.[7] 중심장액성망막병증 환자는 코르티솔 수치가 높은 경향이 있으며,[7] 코르티솔은 스트레스에 대처하는 호르몬이다. 코르티코스테로이드(예: 코르티손)는 염증, 알레르기, 피부 질환, 특정 안과 질환 치료에 사용되지만, 중심장액성망막병증을 유발, 악화, 재발시킬 수 있다는 증거가 많다.[8][9][10] 프레드니솔론을 사용하던 중 망막하 액체가 나타났다가 스테로이드 점안액 중단 후 해결된 사례도 보고되었다.[11] 쿠싱 증후군(코르티솔 수치가 매우 높음) 환자 중 일부에게서 중심장액성망막병증이 발견되기도 했다.[12] 교감신경흥분제 또한 질병 유발과 관련이 있다.[13]
헬리코박터 파일로리(위염 참조) 감염이 발병 후 시력 및 망막 소견과 상관관계가 있다는 연구 결과도 있다.[14][15]
MPGN II형 신장 질환 환자는 신장 사구체 기저막 손상 물질이 망막에 침착되어 중심장액성망막병증을 포함한 망막 이상을 일으킬 수 있다.[16]
임신한 여성에게서 발병하는 경우도 보고된다.[40]
2. 1. 맥락막 비후 스펙트럼 질환
최근 중심장액성망막병증은 맥락막 비후 스펙트럼 질환의 일부로 이해되고 있다.[4][5] 맥락막 비후 스펙트럼 질환의 2단계인 중심장액성망막병증에서는 망막 아래의 혈관이 풍부한 맥락막이 두꺼워지고, 혈관 직경이 확장된다. 특히 깊은 맥락막(할러층)에서 혈관이 팽창한다. 이로 인해 깊은 맥락막에서 얕은 맥락막으로 압력이 증가하여 망막 색소 상피와 망막에 산소와 영양분을 공급하는 미세 혈관(모세혈관)이 손상된다. 또한, 손상된 혈관에서 체액이 새어 나와 망막 아래에 축적될 수 있다.누적된 손상 정도에 따라 맥락막 비후의 다양한 단계가 정의된다.[4][5] 망막 아래 체액 축적 없이 망막 색소 상피에 결함이 있는 경우, 맥락막 비후 색소 상피병증(PPE)이 존재한다. 체액이 축적되면 중심장액성맥락망막병증(CSC)이 발생한다. 맥락막 신생 혈관(CNV)이라는 이차 혈관이 발생하면 맥락막 비후 신혈관병증(PNV)으로 이어진다. 이 새로운 혈관의 일부가 밖으로 부풀어 오르면, CNV 내에서 동맥류가 발생하여 맥락막 비후 동맥류 1형 CNV(또는 폴립형 맥락막 혈관병증(PCV))가 된다.
Siedlecki, Schworm 및 Priglinger에 따르면, 맥락막 비후 질환은 각 전 단계에서 차례로 발전하는 4단계로 나뉜다:[6]
카메라의 필름 역할을 하는 우리 눈의 중심 부분(황반)에 모세혈관의 혈액이 고여서 시력이 떨어지는 증상으로, 주변의 시야는 정상이나 중심 부위가 어둡게 보이거나, 시력이 저하되어 보이거나, 물체가 찌그러져 보이는 증상이다. 중심장액성맥락망막증은 30세 전후의 남성 한쪽 눈에 주로 발생한다.[37] 임상 증상으로는 비교적 중심 암점, 변시증, 소시증 등을 보인다.[37]
안구 내부 점검을 위한 검사로 안저 촬영, 빛간섭 단층 촬영을 한다. 형광 안저 촬영은 어느 혈관이 약한지를 파악하며, 스펙트랄리스 빛간섭단층촬영(OCT)을 사용하여 망막 아래에 고여 있는 물의 양이나 위치, 이상 혈관의 위치까지 진단이 가능하다.[17]
중심장액성망막증은 대체로 예후가 좋은 편이다. 환자의 약 90%가 6개월 안에 정상 시력을 회복한다. 눈의 황반 아래에 고여 있던 액체가 사라지면 시력도 점차 회복된다. 그러나 이 액체가 6개월 이상 지속되면 야간 시력이 나빠지거나, 4~5개월 이상 없어지지 않으면 장기적인 시력에 영향을 줄 수 있다.
중심성장액성망막증의 치료는 크게 경과 관찰, 약물 치료, 레이저 치료로 나눌 수 있다.
3. 증상
4. 진단

진단은 일반적으로 망막의 산동 검사로 시작하며, 광학 단층 촬영법, 플루오레세인 혈관조영술, 인도시아닌 그린 혈관조영술로 확인한다. 혈관조영술 검사에서는 일반적으로 체액 누출과 함께 하나 이상의 형광 반점이 나타난다. 이러한 반점은 사례의 10%-15%에서 고전적인 굴뚝 모양으로 나타난다. 의료 응급 상황인 망막 박리를 배제하기 위해 즉시 감별 진단을 수행해야 한다.
박리의 시간 경과를 기록하기 위해 임상 기록을 작성해야 한다. 영향을 받은 눈은 망막의 상승으로 인한 감소된 초점 거리 때문에 반대쪽 눈보다 더 원시적인 안경 처방을 나타내기도 한다.
인도시아닌 그린 혈관조영술 또는 레이저 도플러 영상을 사용하여 망막 색소 상피 아래의 부어 있는 기저 맥락막 혈관을 드러내고, 치료 결정을 내리는 데 유용할 수 있는 영향을 받은 부위의 망막 건강 상태를 평가할 수 있다.
5. 예후
처음에는 자연적으로 회복되더라도 다음 해에 다시 발생하는 경우가 많다. 재발할 경우 회복 기간이 처음 3개월에서 4개월로 점차 길어지는 등 상황이 나빠질 수 있다.
스피로노락톤은 중심장액성 망막증과 관련된 액체를 줄이는 데 도움이 될 수 있는 무기질 코르티코이드 수용체 길항제이다. Acta Ophthalmologica에 언급된 한 후향적 연구에서 스피로노락톤은 8주에 걸쳐 중심장액성 망막증 환자의 시력을 향상시켰다.[29]
에플레레논은 중심장액성 망막증과 함께 나타나는 망막하 액체를 줄이는 것으로 생각되는 또 다른 무기질 코르티코이드 수용체 길항제이다. International Journal of Ophthalmology에 언급된 한 연구에서 에플레레논은 시간이 지남에 따라 망막하 액체를 수평 및 수직으로 감소시키는 결과를 보였다.[30] 그러나 대규모 연구자 주도 무작위 대조 시험(VICI)에서 에플레레논이 만성 중심장액성 망막증에 유의미한 영향을 미치지 않는 것으로 나타났다.[31][32]
중심성 장액성 맥락망막증은 3~6개월 내에 자연 치유되는 경우가 많다.[38] 누출점을 광응고하면 치유 기간이 단축된다.[38] 다만, 시력 저하가 나타나기 때문에 황반부에는 광응고를 시행하지 않고, 순환 개선제를 사용한다.[38] 스테로이드성 항염증제는 효과가 없다.[38] 수면 부족으로 인해 후유증이 악화되는 경우가 있으므로, 충분한 수면이 필요하다.
6. 치료
6. 1. 경과 관찰
중심성 장액성 맥락망막증은 3~6개월 내에 자연 치유되는 경우가 많다.[38] 환자의 대부분은 망막 아래 액체가 3~4개월 이내에 자연적으로 흡수되며, 시력 회복은 대개 이를 따른다.[25][1]
진행 중인 코르티코스테로이드 치료는 점진적으로 줄여 중단해야 한다. 복용 중인 약물, 특히 비강 스프레이와 크림에 코르티코스테로이드 성분이 있는지 확인하고, 발견될 경우 대체 약물에 대해 의료 전문가의 조언을 구해야 한다.
불규칙한 수면 패턴, A형 성격, 수면 무호흡증, 또는 전신 고혈압이 있는 사람들은 중심장액성망막증에 더 취약한 것으로 알려져 있다. 스트레스 감소와 같은 생활 방식 개선의 효과를 뒷받침하는 증거는 제한적이지만, 충분한 수면을 통해 후유증을 완화할 수 있다.
3~4개월 이내에 자연적으로 또는 상담 결과 액체 흡수가 일어나지 않는 경우 치료를 고려해야 한다.[25][1] 누출점을 광응고하면 치유 기간이 단축되지만,[38] 시력 저하가 나타나기 때문에 황반부에는 광응고를 시행하지 않고, 순환 개선제를 사용한다.[38] 스테로이드성 항염증제는 효과가 없다.[38]
6. 2. 약물 치료
코르티코스테로이드는 염증, 알레르기, 피부 질환 및 특정 안과 질환 치료에 사용되는데, 중심장액성망막증을 유발, 악화, 재발시킬 수 있다는 증거가 많다.[8][9][10] 따라서 스테로이드 약물이 원인인 경우 해당 약물 사용을 중단하거나 대체 약물로 변경한다.
순환 개선제는 혈액 순환을 개선하여 증상 완화를 돕는다.[38]
무기질 코르티코이드 수용체 길항제인 스피로노락톤, 에플레레논 등이 망막하 액체 감소에 효과가 있을 수 있다. 다만, 에플레레논은 대규모 임상 연구에서 만성 중심장액성 망막증에 유의미한 효과를 보이지 못했다.
비스테로이드성 소염진통제 (NSAIDs)인 케토롤락, 디클로페낙, 브롬페낙 등의 점안액이 사용될 수 있지만, 효과에 대한 근거는 제한적이다.[33]
6. 3. 레이저 치료
레이저 광응고술은 모세 혈관의 손상된 부분을 태워 막는 방법으로, 3~4개월 후에도 자연 치유되지 않을 때 사용된다. 단, 눈의 초점 부위(중심와)와 손상 부위가 충분히 멀리 떨어져 있어야 한다. 이 시술은 시력을 영구적으로 손상시킬 위험이 있으며, 재발 방지 효과도 아직 검증되지 않았다.[24][25]
동공 통과 열치료(TTT)는 레이저 광응고술의 대안으로 제시되었으나, 효과에 대한 근거는 제한적이다.[26]
광역학 치료(PDT)는 베르테포르핀이라는 광민감제를 정맥 주사 후 특정 파장의 레이저를 조사하여 비정상적인 혈관을 선택적으로 파괴하는 방법이다. 2003년에 중심장액성망막증에 처음 보고되었으며,[19] 이후 전량 PDT와 저용량 PDT (반량, 반 유량, 반 시간)가 사용되고 있다. 저용량 PDT는 합병증 발생 가능성이 낮고 효과적인 치료법으로 간주된다.[20][21] PLACE 임상 시험에서는 반량 광역학 치료가 고밀도 미세 펄스 레이저보다 우수한 결과를 보였다.[22] 인도시아닌 그린 혈관조영술은 환자의 PDT 반응 예측에 사용될 수 있다.[25][23]
레이저 광응고술은 누출이 중심와로부터 안전한 거리에 있고, 누출원이 하나 또는 소수인 경우에 고려할 수 있다. 그러나 중심 황반 근처에 누출이 있거나 누출이 광범위한 경우에는 적응증이 아니다. 레이저 광응고술은 시술 부위의 시력을 영구적으로 손상시킬 수 있지만, 주의 깊게 조절된 레이저는 손상을 제한할 수 있다.[24] 그럼에도 불구하고, 중심 시야의 누출에는 선호되지 않으며, 일부 의사들은 구식 치료법으로 간주한다.[25]
황색 마이크로펄스 레이저는 일부 연구에서 가능성을 보였으나, 추가적인 연구가 필요하다.[27] 코크란 리뷰에서는 반량 PDT 치료가 급성 중심장액성망막증 환자의 시력 개선 및 재발 감소에 효과가 있다는 낮은 품질의 증거를 발견했다. 또한, 마이크로펄스 레이저 치료도 시력 개선 효과를 보였다.[28]
7. 예방
눈의 스트레스를 줄이려면 강한 햇빛으로부터 눈을 보호하기 위해 선글라스를 사용해야 한다. 컴퓨터를 사용할 때는 컴퓨터용 블루 라이트 차단 렌즈를 사용하거나, 자주 눈을 깜박이거나, 눈 운동을 수시로 하고, 지압을 해 주는 등 평상시 눈의 스트레스를 줄여 주는 것이 중요하다. 선글라스의 경우, 어두워지는 늦은 오후나 비 오는 날에는 옅은 갈색 선글라스를, 이른 아침의 강한 햇살이나 밝은 대낮, 해변 같은 곳에서는 짙은 회색 선글라스를 착용하여, 상황에 맞게 적당량의 빛을 차단하여 눈의 피로를 최소화하는 것이 필요하다.
참조
[1]
논문
Central serous chorioretinopathy
2008-03
[2]
논문
Central serous chorioretinopathy in women
1996-01
[3]
논문
Non-resolving, recurrent and chronic central serous chorioretinopathy: available treatment options
2019-07
[4]
논문
Pachychoroid disease
2019-01
[5]
논문
Spectrum of pachychoroid diseases
2018-10
[6]
논문
The Pachychoroid Disease Spectrum-and the Need for a Uniform Classification System
2019-12
[7]
논문
Endogenous cortisol profile in patients with central serous chorioretinopathy
1997-11
[8]
논문
Central serous chorioretinopathy after epidural steroid injection
2005-08
[9]
논문
Visual loss due to central serous chorioretinopathy during corticosteroid treatment for giant cell arteritis
2005-08
[10]
논문
Coroidopatía serosa central como complicación de epitelitis en tratamiento con corticoides
2005-04
[11]
논문
Steroid-induced central serous retinopathy
2011-09
[12]
논문
Central serous chorioretinopathy in endogenous hypercortisolism
1993-09
[13]
논문
Central serous chorioretinopathy associated with administration of sympathomimetic agents
2003-07
[14]
논문
"[Prevalence of Helicobacter pylori in central serous chorioretinopathy and diffuse retinal epitheliopathy: a complementary study]"
2004-12
[15]
논문
Central serous chorioretinopathy and Helicobacter pylori
[16]
논문
Visual impairment caused by retinal abnormalities in mesangiocapillary (membranoproliferative) glomerulonephritis type II ("dense deposit disease")
2003-08
[17]
논문
Choroidal vasculature imaging with laser Doppler holography
[18]
논문
Central serous chorioretinopathy: Towards an evidence-based treatment guideline
2019
[19]
논문
Indocyanine green angiography-guided photodynamic therapy for treatment of chronic central serous chorioretinopathy: a pilot study
[20]
논문
Half-dose verteporfin photodynamic therapy for acute central serous chorioretinopathy: one-year results of a randomized controlled trial
2008-10
[21]
논문
Long-term results of half-dose photodynamic therapy for chronic central serous chorioretinopathy with contrast sensitivity changes
2013-05
[22]
논문
Half-Dose Photodynamic Therapy versus High-Density Subthreshold Micropulse Laser Treatment in Patients with Chronic Central Serous Chorioretinopathy: The PLACE Trial
2018-05-20
[23]
논문
Association between the efficacy of photodynamic therapy and indocyanine green angiography findings for central serous chorioretinopathy
2010-03
[24]
논문
Retinal sparing by selective retinal pigment epithelial photocoagulation
1999-08
[25]
논문
When to Treat and Not to Treat Patients With Central Serous Retinopathy
http://bmctoday.net/[...]
2010-04
[26]
논문
Transpupillary thermotherapy in the treatment of central serous chorioretinopathy
[27]
웹사이트
A New Treatment for Chronic Central Serous Retinopathy
http://bmctoday.net/[...]
Retina Today
2013-08-11
[28]
논문
Interventions for central serous chorioretinopathy: a network meta-analysis
2015-12
[29]
논문
Spironolactone in the treatment of non-resolving central serous chorioretinopathy: a comparative analysis
[30]
논문
Oral eplerenone for the management of chronic central serous chorioretinopathy
[31]
논문
Eplerenone for chronic central serous chorioretinopathy in patients with active, previously untreated disease for more than 4 months (VICI): a randomised, double-blind, placebo-controlled trial
2020-01
[32]
웹사이트
VICI Trial YouTube video
https://twitter.com/[...]
[33]
웹사이트
Retinal Physician - Central Serous Chorioretinopathy and Topical NSAIDs
http://www.retinalph[...]
2017-10-15
[34]
논문
Estimation of current and post-treatment retinal function in chronic central serous chorioretinopathy using artificial intelligence.
[35]
논문
Long-term macular function in eyes with central serous chorioretinopathy
2005-08
[36]
논문
Long-term follow-up of central serous chorioretinopathy (CSCR)
[37]
서적
イラスト眼科
文光堂
[38]
서적
医師国家試験のためのレビューブック マイナー
メディック・メディア
[39]
웹사이트
中心性漿液性脈絡網膜症
http://www.nichigan.[...]
[40]
웹사이트
中心性漿液性脈絡網膜症
http://www.nichigan.[...]
[41]
저널
Central serous chorioretinopathy
[42]
저널
Central serous chorioretinopathy in women
[43]
저널
A New Treatment for Chronic Central Serous Retinopathy
http://bmctoday.net/[...]
Retina Today
2010-02
본 사이트는 AI가 위키백과와 뉴스 기사,정부 간행물,학술 논문등을 바탕으로 정보를 가공하여 제공하는 백과사전형 서비스입니다.
모든 문서는 AI에 의해 자동 생성되며, CC BY-SA 4.0 라이선스에 따라 이용할 수 있습니다.
하지만, 위키백과나 뉴스 기사 자체에 오류, 부정확한 정보, 또는 가짜 뉴스가 포함될 수 있으며, AI는 이러한 내용을 완벽하게 걸러내지 못할 수 있습니다.
따라서 제공되는 정보에 일부 오류나 편향이 있을 수 있으므로, 중요한 정보는 반드시 다른 출처를 통해 교차 검증하시기 바랍니다.
문의하기 : help@durumis.com